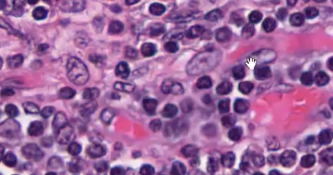
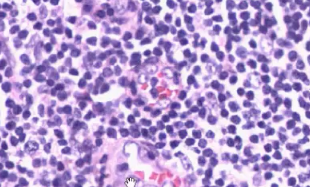
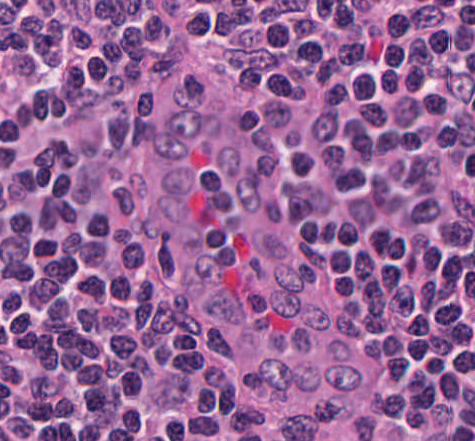

How do you differentiate between adult thymus and infant thymus
From the abundance of adipose tissue
What are the densely staining and lightly staining regions in the thymus
Densely staining are the cortex whereas the lightly staining is the medulla. Cortex is densely staining because of the high number of lymphocytes and their high nucleus to cytoplasm ratio

Starry sky appearence of the cortex in the thymus due to the presence of macrophages

Macrophages.
Most cell death occurs in the cortex of the thymus, macrophages carry out this function
What is the distinguishing feature of Medulla in the thymus? What is the name of this structure and what is its role

Hassles corpuscles
Important in Regulatory T cell development
What is this structure

Epithelia reticular cells, important in thymocytes education
What is the stroma of the thymus consist of
Epithelial cells
What is the stroma of the spleen consist of
Reticular cells
What is the stroma of the lymph nodes consist of
Reticular cells
What is this structure?
What is the distinguishing feature of this structure?
Macrophage, the distinguishing feature is the debris found around the cell.
What kind of cells form the Hassel’s corpuscle and what is a marker to check for that?
Epithelial cells, keratin since hassale’s corpuscles are keratinized
How do you differentiate between thymus and lymph node
Thymus doesnt have any germinal centers
What is the difference between normal and reactive lymph node?
Explain the details of the structures that are found in the reactive lymph node
Germinal centers are obvious in a reactive lymph node, the B cells in the center of the germinal centers are differentiating and pumping out antibodies whereas the germinal center itself is lined by light staining immature B cells
HEV
What is the area surrounding the germinal centers in the lymph node
It is called the paracortex, it is the place where dendritic cells present antigens to the T cells
Know the structures of follicles and their types on lymph nodes and what is their function
Antigens presented to B cells at this site by follicular dendritic cells, follicles encircle the germinal centers in reactive lymph nodes

What cells are found at different sites of the lymph node
Tonsils are examples of?
Mucosa Associated Lymphoid Tissue (MALT)
What are the 3 pais of tonsils
Pharyngeal, Palantine and Lingual tonsils
How to differentiate between tonsils and other structures of the immune system
Tonsils have characteristic crypts

How can we differentiate between pharyngeal tonsil and palantine tonsil
Palantine has stratified squamous epithelium whereas the pharyngeal has ciliated pseudostratified columnar epithelium
What are these and what are their funciton
Cuboidal epithelium of HEVs in tonsils, delivery of lymph to tonsils
MALT, SALT, GALT, etc
These are transient lymphoid associated structures found in Gut (GALT), Skin (SALT), etc where they form germinal centers and stay until the infection is fought off.
Peyer’s patch
Permanent structure found underneath the lumen of the ilium where the dendritic cells present antigens and B cells and T cells proliferate to fight off the antigen